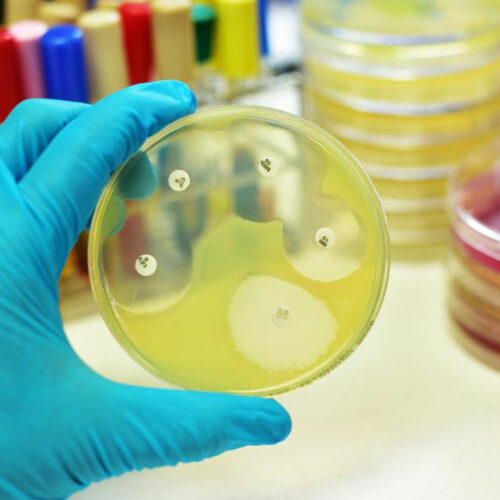
Know about the Different Types of Meningitis and Its Prevention

Know about the Different Types of Meningitis and Its Prevention
The disease meningitis is an ailment where the membrane around the brain and the spinal cord swell due to parasites, fungi or some kind of injury. Meningitis due to viral infections happens to be the most common of all. Bacterial meningitis is an ailment that happens to be more common in young children.